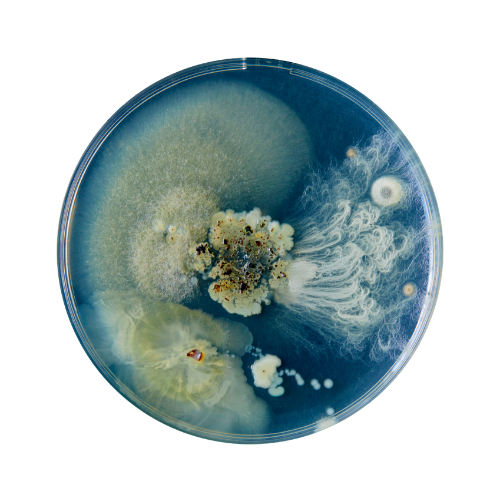

THE THREAD

I'm Gaja
the heart & creative spirit of PREM CHANDRA
For most of my life, I moved away from what I felt. Creative practice became a place where that began to shift – a way of translating what was difficult to name into something I could meet. Working with food and plants as living material opened a deeper attention to the natural world.
Over the past decade, this dialogue with nature has become a dialogue with myself – with my body, my cycles, and the parts of myself I had learned to look away from. This is why, for me, creativity is not separate from healing – it becomes the lens through which I understand and navigate life.
Within this understanding, Toltec wisdom holds that every person is an artist, and that the art we make is the story of our lives. I see healing as part of that artistry – a creative act of uncovering, rearranging, and reimagining ourselves after what breaks us open.
In practice, this unfolds as a shared journey, a quiet act of walking each other home.
A way of being
The practices I return to – food, photography, poetry – have each taught me to stay with my experience as it unfolds, shaping how I hold space for others.
In all I do, I approach nature as a living intelligence that teaches through change, repetition, decay, and renewal. Paying attention outward – to plants, land, cycles, and material – draws me inward too: to the body, to memory, to what is usually overlooked.
Cooking, with plants as my medium, is where that relationship becomes most intimate – emotions and distant memories translated into tangible form. Like perishable sculpture, fleeting in nature, leaving a lasting imprint on body and heart.
Photography and poetry extend this gesture – bearing witness to what passes, suspending it in time.
In my work with others, I do not seek to resolve or instruct, but to create conditions for pause and recognition – where inner and outer worlds can be sensed as part of the same field.
Lineage & learning
Jikiden Reiki (Shoden & Okuden), Jikiden Reiki UK Association
200-hour Sound Meditation Teacher Training, Yoga Allience
Folk herbalism (ongoing), Las Kobiet
Plant-based Culinary Arts, PLANTLAB
MSc in International Business, Hult International Business School
MSc in Occupational Psychology, Goldsmiths, University of London
BSc (Hons) in Psychology, Queen Mary University of London
Classical music education, (flute & guitar)
Each of these studies has become a thread in the tapestry of my work – grounding intuition with knowledge,
and weaving science, creativity, and tradition into the practices I hold today.

